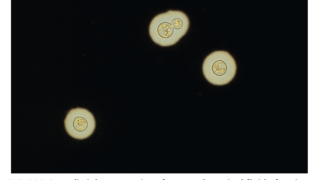

糖尿病・性腺機能低下症・副腎皮質機能低下症・副腎皮質機能低下症を合併することがある。
糖尿病が最も一般的で、m.3243A>G変異による母系遺伝に伴う糖尿病と難聴(MIDD)が重要。
非肥満の50歳以下の糖尿病発症で1型糖尿病の自己抗体陰性かつ感音性難聴を伴う場合は血中・尿中のm.3243A>G変異を調べる。
概論
ミトコンドリア病の患者において内分泌疾患を認めることがある。糖尿病がメインであるが、他に性腺機能低下症・副腎皮質機能低下症・副甲状腺機能低下症などがある。

糖尿病
1992年に初めて糖尿病とミトコンドリアDNAの変異の関連が報告された。
1996年にm.3243A>G変異による母系遺伝に伴う糖尿病と難聴(MIDD, maternally inherited diabetes and deafness)が新しい糖尿病の亜型として提唱された。
MIDDの有病率は日本の糖尿病患者の1.5%で、糖尿病と難聴の既往歴・家族歴を持つ患者に限定したスクリーニングでは平均5%に増加する。
糖尿病の平均診断年齢は39歳(12-67歳)で、一般的に中年初期に発症することが多い。
糖尿病の表現型は多様かつ動的。同じ血縁内でもインスリン依存性、非インスリン依存性糖尿病の発症があり様々。
m.3243A>G変異のMIDD患者の13%が診断時からインスリン治療を必要とし、残りの非インスリン依存性患者の45%は平均4.2年の間にインスリン治療に移行した。
ある横断研究では、MIDD患者の41%が非インスリン依存性と分類され、13%が診断時からインスリンを必要とし、8%が糖尿病性ケトアシドーシスを呈した。
このように糖尿病の表現型は様々だが、m.3243A > GのMIDD患者は発症時に常に非肥満であることは重要。
本邦の研究では、MIDD患者の平均BMIは20.4 (±3.1 SD)であった。
基本的に抗GAD抗体など1型糖尿病の自己抗体は陰性。
m.3243A > G 変異は、蝸牛機能障害に続発する左右対称の感音性難聴を引き起こす。
難聴の平均発症年齢は26歳や34歳と報告されている。
高音域の損失から始まり、大半の患者で経時的に悪化する。
感音性難聴はm.3243A > Gに起因するミトコンドリア糖尿病患者の主要な特徴であり、横断的研究において臨床的に明らかな難聴の有病率は86%から98%であった。
難聴は糖尿病の診断に平均6年先行したという報告がある。
よって成人期初期に糖尿病発症前に出現した両側性感音難聴の病歴は、MIDDを強く疑う所見となる。
m.3243A > G変異をもつミトコンドリア病の40%に糖尿病を認める。
他の変異による糖尿病の報告は、m.14709T > C 54%(7/13)、単一で大きいmtDNA欠失 11%(6/55)、m.8344A > G:10%(3/29)、複数のmtDNA欠失 7%(3/43)などがある。
MIDD29人を解析した場合、m.3243A > G 変異が21人と大多数であり、残り8人はミトコンドリア点変異(m.8344A > Gとm.12258C > A)、または単一で大きなmtDNA欠失であった。
本邦のm.3243A>G変異を伴うミトコンドリア糖尿病113例を解析した報告では、平均BMI18.6、糖尿病の発症は32.8±12.4歳、母方の糖尿病の家族歴は68%、インスリン治療が86.1%、抗GAD抗体は陰性。診断からインスリン治療開始まで平均3年。両側の感音性難聴を92%に認め、難聴の平均診断年齢は33.2歳。母方の難聴の家族歴は82%。他の臓器病変は心筋症30.4%、心伝導障害26.8%、神経筋疾患23.2%(MELAS12.5%、外眼筋麻痺8.9%)、基底核石灰化71.4%。


糖尿病合併症
m.3243A > G 変異体に起因する MIDD の日本人患者では、末梢神経障害58%、糖尿病性網膜症62%、腎症56%と高い有病率が報告された。
糖尿病コントロール群と比べm.3243A > G変異を有する患者では糖尿病性眼疾患の有病率が低下し、腎機能障害の有病率が上昇したとされる。
巣状分節性糸球体硬化症(FSGS)の併発の報告があり、そのために有病率が上がっているのかもしれない。

低身長
ミトコンドリア病では一般集団と比べ-0.49SD(95%CI、-0.58〜-0.39)身長が低い。
ミトコンドリア病の成人の10人に1人が-2SD以下の身長。
中でもm.3243A > G変異をもつ場合は有意に最終身長が低くなる傾向がある。
GH欠乏が原因という報告もあるが、GH欠乏を伴わない症例も報告されている。
GH欠乏がある場合は補充を検討する。
副甲状腺機能低下症
副甲状腺機能低下症は、散発的な単一mtDNA欠失に起因するKearns-Sayre症候群との関連が報告されている。
剖検標本では、副甲状腺は萎縮しているか、存在しないことさえある。
副腎皮質機能低下症
最近の文献でミトコンドリア病と副腎皮質機能低下症を合併した14例の報告がある。
10例はmtDNA欠失、2例は劣性POLG変異、1例は劣性GFER変異、1例はm.8344A>G変異の患者であった。副腎自己抗体は陰性。
慢性・反復性の電解質異常はミトコンドリア病の特徴であり、副腎皮質機能低下症が尿細管機能障害など他の因子とともに潜在的な原因の可能性がある。
不妊・性腺機能低下症
英国のミトコンドリア病患者コホートにおいて15歳以上の女性の出生率を調べた研究では一般集団との有意差は認めなかった(63.2/1000人年 vs 67.2/1000人年, p=0.36)。最も重症の保因者の場合も有意差はなかった。
男性患者では生殖成功率は一般集団と比べ65%であったが、精子の運動性や病気の重症度によるパートナーとしての魅力への影響など多くの要因が考えられる。
ミトコンドリア病患者全体としては一般集団と大きな差はなかったが、一部の遺伝子の変異では男女ともに生殖能力に影響を与えることが報告されている。
mtDNA単一大規模欠失では約20%の患者が臨床的・生化学的な性腺機能低下症を示す。
AARS2の変異体に関連する白質脳症の患者コホートでは、すべての女性患者が30歳以前に卵巣不全による原発性または続発性の無月経を発症した。
最も一般的な核遺伝子関連ミトコンドリア病の1つであるPOLG遺伝子の優性変異は、原発性卵巣不全および原発性精巣不全と関連している。
感音性難聴に加え、男性または女性に性腺形成不全が認められる場合、稀な常染色体劣性遺伝のミトコンドリア異常症であるPerrault症候群を疑う。
Perrault症候群の多くは分子遺伝学的診断がなされていない。
現在Perrault症候群では6つの遺伝子異常が報告されている(TWNK,CLPP,LARS2,HARS2,ERAL1,HSD17B4)。
小脳失調症、感覚性末梢神経障害、知的障害、白質ジストロフィーなどの神経学的特徴を伴うことがある。
ミトコンドリア病患者では、他の全身症状が目立つ場合、性腺機能低下症が見逃されていることがあるので注意が必要。
妊娠
m.3423A > G変異が妊娠転帰に及ぼす影響について、コホート研究が2件発表されている。
m.3243A > G変異を持つ女性の妊娠では、妊娠糖尿病が16%と有意に多く、3分の1以上に高血圧を認めた。正常な経膣分娩は半数程度で、緊急帝王切開が約25%を占めた。37週以下の早産が53.3%と多かった。
もう一つのコホート研究では,25.3%が早産(妊娠32週以下が5.5%),12%が子癇前症,11%が妊娠糖尿病を発症したとされる。
よってm.3243A > G変異体を有する妊婦は、出生前合併症のリスクが高いため産科と内科で厳重な管理が必要となる。
非内分泌疾患の特徴
神経
ミトコンドリア病患者の約80%に神経病変を認める。
小児の神経発達遅延、筋疾患、成人の運動不耐症などをよく認めるが、非特異的である。
一方、Leber遺伝性視神経症における連続的な無痛性視力低下、Leigh症候群における発達退行と対称的な基底核信号異常、MELAS症候群における脳卒中様エピソードなどは強くミトコンドリア病を疑う所見となる。
心臓
ミトコンドリア病の心疾患には心筋症、WPW症候群、心ブロックなどがある。
無症候性左室肥大やWPW症候群は症状として現れないので、m.3243A > Gやm.8344A > Gのような一般的なmtDNA変異体の心疾患スクリーニング時にみつかる。
一度房室ブロックから完全房室ブロックまでの進行性の伝導障害はKearns-Sayre症候群を示す単一大規模mtDNA欠失と関連する。
260人のレトロスペクティブ研究において、m.3243A > Gと単一大規模mtDNA欠失をもつ患者では心不全・心停止・突然死などの主要な心疾患のリスクが高いことが示された。
例えば、劣性 AGK 変異体による Senger 症候群やホモプラズム m.4300G > A 変異体では心病変の症状が最も顕著に現れることもある。
心臓病変の早期認識と治療介入は、心臓死が病原性mtDNA変異による成人ミトコンドリア病で最も多い死因のままであるため、極めて重要となる。
心病変の発現リスクは遺伝子型に特異的であることも重要であり、成人の慢性進行性外斜視やmtDNA維持障害に関連する多くの一般的な核遺伝子欠損では心病変は稀である。
消化管
ミトコンドリア病の成人患者では、早期の満腹感、食欲不振、腹部膨満感、慢性便秘などの消化管運動障害の症状が比較的よくみられる。
一部の患者は、胃不全麻痺や腸閉塞として現れる重度の腸管運動障害を発症することがある。英国のあるコホート研究では、m.3243A > Gの症例の50%において、脳卒中様のエピソードと同時に腸閉塞を発症することが確認されている。
mtDNA枯渇に続発する肝動脈症候群では、肝疾患は重篤で、低血糖、肝機能検査異常、凝固障害、乳酸アシドーシスなどが幼児期、典型的には乳児期に頻繁に発現する。
肝移植を必要とする劇症型肝不全に至ることもある。
腎臓
ミトコンドリア病の原因となるいくつかの遺伝子欠損では、腎臓病変が臨床表現型の一部を形成する。
腎疾患としては、ステロイド抵抗性ネフローゼ症候群、FSGS、近位および遠位尿細管アシドーシス、高血圧を伴う嚢胞性変化などがある。
m.3243A > G 変異の場合、糖尿病とは無関係に慢性腎臓病が出現したり、糖尿病の発症に先行することがある。
腎臓病患者の一部は末期腎不全に移行することがあり、透析や腎移植を含む腎代替療法が必要となることがある。



MIDDの診断アルゴリズム
非肥満の50歳以下の糖尿病発症で1型糖尿病の自己抗体陰性かつ感音性難聴を伴う場合は血中・尿中のm.3243A>G変異を調べる。陽性であれば診断。陰性の場合は神経遺伝学チームと協議を行い、単一大規模mtDNA欠失などの他のmtDNA異常を調べるか決める。
m.3243A>G変異はスクリーニングはEDTA血液サンプルを使って行われることが多いが、血液中のヘテロプラスミーのレベルが検出下限以下であることがある。その場合は尿路上皮細胞や骨格筋など他の組織での検査が必要となる場合がある。

診断時のスクリーニング

マネジメント
内分泌疾患のマネジメント
ホルモン欠乏に対するマネジメントは一般的な内分泌疾患と同様に補充の対応を行う。
糖尿病に関しては、診断時にインスリン欠乏(体重減少、ケトーシス)を示す場合は通常の1型糖尿病と同様にマネジメントを行う。
非インスリン依存の場合は2型糖尿病のように治療を行うが、いくつか注意点がある。
1. インスリン依存に移行する可能性があるので、定期的に分泌能をフォローする。
2. 乳酸アシドーシスのリスクがあるので、特に急性疾患時にはメトホルミンの使用を控える。
3. ミトコンドリア糖尿病患者はSU薬によく反応するが、反復性低血糖になりやすい人もいる。よってSU薬を使う場合は低用量で用いて、血糖値のモニタリングが出来るようにする。
4. 多くの患者は非肥満かつ消化器症状を訴えることがあるのでGLP-1作動薬よりもDPP-4阻害薬のほうが使いやすい。
5. SGLT-2阻害薬は腎臓・心臓保護に有効とされるが、ミトコンドリア病患者に対するRCTはない。ただ血糖コントロール改善に有効であったとする報告はある。ケトアシドーシスのリスクを高めるので、ケトン体測定と内服中止についての教育が重要。

全般的なマネジメント
一般的にミトコンドリア病のマネジメントは支持療法となる。
ミトコンドリア病には脳卒中様発作・難治性seizures・脳幹クリーゼ(Leigh症候群)、重度の代謝性アシドーシスに伴う多臓器不全などの緊急事態が起きうる。
これらのリスクについて本人・家族・医療従事者が知識をつけ、脳卒中様発作に対する抗けいれん薬静注や適切なモニタリングや支持療法を速やかに開始できるようにする必要がある。
感音性難聴、心臓病変、慢性腸管運動障害などは進行性であり、定期的な検査が必要。
左室肥大や伝導障害など心臓スクリーニングが陽性であれば、重症化する可能性があるため専門医への紹介が必要。
中枢神経系の重度の障害や筋力低下がある場合は呼吸不全や嚥下機能低下を起こしうるので、呼吸機能と嚥下機能の評価を定期的に検討する。
有効性を示す強固な臨床試験の証拠はないが、「mitococktails」と呼ばれるマルチビタミンと補酵素の投与が推奨され、患者・家族に広く受け入れられている。
注意を要する薬剤

生殖の選択肢
まず核遺伝子の病原性変異をもつ患者とミトコンドリア遺伝子の病原性変異をもつ患者かで分かれる。核遺伝子の場合は優性遺伝か劣性遺伝かでアドバイスが異なり、国によっては出生前検査や着床前遺伝子検査などが選択肢となる。
ミ トコンドリア遺伝子の変異で患者が男性の場合は、母系遺伝であり父親からの遺伝の報告はないので心配する必要はない。女性の場合は遺伝子変異よってリスクが変わる。
単一大規模mtDNA欠失の多くは散発的であり、遺伝しない可能性は十分にある。
m.3243A>G変異や他の多くの変異ではリスクは様々で、実際にすべての子供に病原体変異を遺伝することになる。
出生前診断では羊水穿刺や絨毛膜絨毛サンプリングで得られた組織のヘテロプラスミーの度合いを調べることができる。例えば単一大規模mtDNA欠失をもつ患者のように遺伝リスクが低い場合は、遺伝がないことを確認したい場合によい選択肢となるが、1%程度流産のリスクを伴う手技であることも考慮が必要。
着床前遺伝子検査ではヘテロプラスミーの度合いが低い胚細胞を選び胚移植を行う。
近年、ミトコンドリア提供とよばれるもう一つの選択肢が登場した。
これらの医療は国によって何が許されているか選択肢が異なる。


糖尿病・性腺機能低下症・副腎皮質機能低下症・副腎皮質機能低下症を合併することがある。
糖尿病が最も一般的で、m.3243A>G変異による母系遺伝に伴う糖尿病と難聴(MIDD)が重要。
非肥満の50歳以下の糖尿病発症で1型糖尿病の自己抗体陰性かつ感音性難聴を伴う場合は血中・尿中のm.3243A>G変異を調べる。
〈参考文献〉
Endocrine manifestations and new developments in mitochondrial disease. Endocr Rev. 2021 Oct 13:bnab036. PMID: 34644386.
Patient care standards for primary mitochondrial disease: a consensus statement from the Mitochondrial Medicine Society. Genet Med. 2017 ;19:10. PMID: 28749475.
Clinical features of diabetes mellitus with the mitochondrial DNA 3243 (A-G) mutation in Japanese: maternal inheritance and mitochondria-related complications. Diabetes Res Clin Pract. 2003;59:207-17.PMID: 12590018.